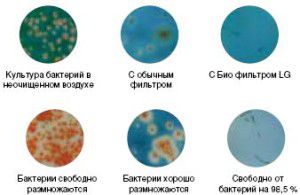
le résultat des filtres du climatiseur colonne LG

Depuis plusieurs décennies, le géant de l'industrie mondiale de l'électroménager LG fournit au marché d'excellents équipements de climatisation, qui sont testés en plusieurs étapes et ensuite seulement commercialisés. Tout climatiseur LG est un appareil qui dépasse les attentes et de nombreuses technologies modernes en termes de caractéristiques et de fonctionnalités.
Les produits de la société comprennent à la fois de nombreuses séries d'appareils de climatisation domestique, à la fois industriels et semi-industriels, dont nous parlerons plus tard.
- Split systems LG : gamme, caractéristiques, spécifications
- Climatiseurs muraux lg
- Climatiseur à cassette LG
- Systèmes de division de canal
- Systèmes de division de colonne
- Systèmes de séparation au sol et au plafond
- Installations mobiles et fenêtres LG
- Systèmes multi-split LG
- Systèmes multizones LG
- Instructions pour les climatiseurs et les télécommandes LG
- Schémas de câblage du climatiseur LG
- Réparation de climatiseur LG
- Avis sur les climatiseurs LG
Split systems LG : gamme, caractéristiques, spécifications

Récemment, le fabricant s'est concentré sur les climatiseurs à onduleur LG, car ils sont les plus demandés par les acheteurs. Qu'est-ce qui attire les gens vers cette technologie climatique ? Tout d'abord, leurs caractéristiques de performance. Grâce au contrôle du compresseur Inverter, ces appareils permettent d'économiser jusqu'à 60 % d'énergie. La plupart des nouvelles gammes de climatiseurs split onduleur LG sont équipées d'une fonction de refroidissement instantané JET COOL, qui vous permet de changer la température dans une pièce en seulement 5 minutes.
Un autre avantage important est une diminution significative de l'humidité. Grâce à l'utilisation du compresseur de dernière génération, il se déroule sans hypothermie inutile de la pièce.
Climatiseurs muraux lg

Les climatiseurs de la série ART COOL de LG sont devenus les plus populaires ces dernières années. En plus des caractéristiques mentionnées ci-dessus, ces appareils présentent de nombreux avantages et bénéfices :
- Système de purification d'air à plusieurs niveaux - filtres plasma antibactériens, antiviraux, antiallergéniques, désodorisants + nettoyage automatique ;
- Des solutions de conception audacieuses pour l'apparence des unités de climatisation. Les climatiseurs LG ART COOL GALLERY ont un panneau avant décoratif sous la forme d'une image avec des images changeantes. ART COOL STYLIST est équipé d'un rétroéclairage LED avec 26 couleurs différentes ;
- Niveau de bruit. Tous les climatiseurs muraux à onduleur LG sont assez silencieux. Et les lignes de modèles ART COOL STYLIST, SLIM et MEGA ont un niveau sonore de seulement 19 dB grâce à la conception profilée du ventilateur, qui assure une sortie d'air uniforme de l'appareil ;
- Répartition volumétrique des flux d'air à travers les volets de guidage avec 6 positions différentes verticalement et 5 horizontalement pour ART COOL MEGA ;
- Tous les climatiseurs LG ART COOL sont beaucoup plus faciles à monter au mur grâce à la conception simplifiée des panneaux du module intérieur.
Mais les climatiseurs à onduleur LG ne sont pas les seuls à avoir des caractéristiques positives et des options pratiques. Les modèles sans onduleur tels que STANDARD, STANDARD RETAIL et PLASMA se distinguent par un refroidissement rapide et uniforme, un mode nuit (STANDARD), un nettoyage automatique des cavités de l'échangeur de chaleur contre les moisissures, la poussière et les germes (PLASMA) et un contrôle pratique.
Climatiseur à cassette LG

Les systèmes split LG de type cassette onduleur et standard peuvent desservir efficacement aussi bien les locaux d'habitation avec de hauts plafonds et une superficie allant jusqu'à 150 m², que les immeubles semi-industriels ou de bureaux.
Pour installer l'unité intérieure, vous aurez besoin d'une structure de plafond suspendu, dans l'un des carrés dont toutes les communications et l'appareil lui-même seront cachés, tout en maintenant l'intégrité de l'intérieur.
Les climatiseurs à cassette de LG, à la fois standard et à onduleur, ont de bonnes puissances nominales, une consommation d'énergie efficace, une longueur de canalisation accrue et une conception technologique et compacte d'un réseau de distribution décoratif.
Le climatiseur à cassette LG a un avantage incontestable - une distribution d'air de haute qualité sur les quatre côtés. Ceci est assuré par un dispositif d'obturation amélioré. Ils sont devenus plus longs et plus étroits. L'angle d'inclinaison et la vitesse de déplacement de chaque rail de guidage sont facilement réglables. Vous pouvez contrôler manuellement l'intensité du soufflage et régler les valeurs en fonction de la hauteur du plafond.
Il convient de rappeler que la distance minimale entre le plafond et la structure du faux plafond doit être de 25 cm, ceci est écrit dans les instructions.
Systèmes de division de canal

Chez LG, tous les climatiseurs à gaine se distinguent par leur facilité d'installation, leur faible niveau sonore grâce à la conception du ventilateur décrite ci-dessus et une approche économique de la consommation d'énergie.
Ce système de climatisation peut être installé dans n'importe quel bâtiment avec de nombreuses pièces allant de 25 à 160 m², sans perturber la vue d'ensemble. Ce qui caractérise les climatiseurs à canal LG, c'est l'indépendance par rapport aux nuances architecturales de la pièce et au nombre de communications.
Le principal avantage est le refroidissement simultané d'un bloc de 4 pièces maximum grâce à l'embranchement des conduits d'air + mélange d'air de la rue. Ainsi, les climatiseurs à canal LG peuvent combiner plusieurs pièces en un seul système commun.
Le contrôle de la température est effectué par deux capteurs, dont l'un est intégré au module intérieur et le second est situé sur la télécommande. Le réglage de la pression statique externe permet de maintenir des niveaux de bruit normaux et de bonnes performances à tout moment.
Des options telles que le contrôle de zone et une pompe de drainage haute pression avec une hauteur manométrique jusqu'à 700 mm permettent de contrôler la température dans différentes pièces en même temps et d'évacuer les condensats du système.
Systèmes de division de colonne

Le bloc interne d'une telle scission ressemble à une armoire. Le choix de ce système se justifie si la pièce présente de grands volumes (jusqu'à 200 m²), et que les types d'installation mur ou plafond sont impossibles en raison de ses caractéristiques architecturales. En même temps, cette installation peut devenir un élément décoratif à l'intérieur d'un certain style.
Contrairement aux normes généralement acceptées en termes de paramètres de surface, les climatiseurs à colonne LG sont capables de traiter, selon les instructions, une pièce jusqu'à 280 m².
Les dimensions des climatiseurs à colonne LG dépassent les dimensions des éléments des systèmes split d'autres types, mais en même temps, ils ont la capacité de réfrigération la plus élevée. Leurs avantages et caractéristiques incluent également :
- travailler en mode automatique;
- contrôle par microprocesseur;
- dépoussiéreur à filtre électrostatique;
- compresseur très efficace;
- protection automatique contre les surtensions et les pannes de courant ;
- système d'autodiagnostic;
- modes supplémentaires de type "Sommeil confortable".
LG dispose d'une alimentation en air efficace dans les climatiseurs à colonne : son flux le plus fort est d'abord dirigé du module intérieur vers le haut, puis il est réfléchi par le plafond et se diffuse uniformément dans toute la pièce.
Mais il convient de rappeler que trouver une personne à proximité d'un tel appareil tout en travaillant pour le refroidissement peut constituer une menace de rhume.
Systèmes de séparation au sol et au plafond

Les modules intérieurs des climatiseurs LG, de type sol-plafond, sont installés avec succès à la fois au mur près du sol et au plafond. L'unité extérieure y est reliée au moyen d'un rail en cuivre dans un radiateur. Pour les modèles à faible puissance, l'alimentation va de l'interne vers l'externe, tandis que pour les autres c'est l'inverse. LG produit à la fois des climatiseurs à onduleur et des climatiseurs standard de ce type. Les valeurs de surface des pièces peuvent varier de 25 à 280 m².
Si la forme de la pièce est plus allongée, une fente à un seul fil est montée, dans d'autres cas, une fente à plusieurs fils.
D'ailleurs, certains splits du sol au plafond peuvent réaliser des prises d'air en petits volumes à l'extérieur.
Le flux d'air est parallèle au sol ou le long du plafond, ce qui élimine la formation de courants d'air et le refroidissement excessif du sol. On ne peut pas dire que tous les splits de ce type fonctionnent en silence, mais parmi les appareils qui traitent une surface allant jusqu'à 50 m², il existe des modèles avec un niveau sonore de seulement 20 dB. La plupart des climatiseurs sont équipés de filtres ioniseur, plasma, anti-poussière, nano-argent et vitamine C, qui sont entièrement antimicrobiens.
Les fonctionnalités supplémentaires sont variées : mode turbo, redémarrage automatique avec répétition du programme défini jusqu'à la mise hors tension, déshumidification améliorée par temps humide et mode sommeil confortable avec diminution/augmentation automatique de la température pendant les deux premières heures de fonctionnement.
Installations mobiles et fenêtres LG

Comme tous les autres fabricants, LG propose plusieurs gammes de climatiseurs mobiles et de fenêtre, qui étaient auparavant pratiquement le seul salut pour les gens.
Contrairement aux splits, les climatiseurs mobiles LG ne nécessitent pas d'installation particulière et sont un monobloc avec une sortie d'air pour l'évacuation de la chaleur, placé dans une fenêtre (fenêtre) ou un trou dans le mur. Ces structures peuvent être transférées, si nécessaire, dans d'autres locaux.
En plus du refroidissement, le climatiseur mobile de LG déshumidifie, ventile et réchauffe l'air. Il dispose d'un système de filtration en plusieurs étapes et de modes supplémentaires - une minuterie quotidienne et une nuit de sommeil confortable.
Les climatiseurs de fenêtre LG ne sont pas moins demandés qu'autrefois. Cela est dû à leur faible coût et à leur facilité d'installation. Habituellement, un tel dispositif est un monobloc placé dans une ouverture de fenêtre. Ses niveaux de bruit sont nettement plus élevés que ceux des systèmes split, mais en même temps, il fournit un apport constant d'air frais.
Le climatiseur de type fenêtre LG ne refroidit que les petites pièces dont la superficie ne dépasse pas 25 m².
Systèmes multi-split LG

Dans la climatisation des bâtiments de bureaux, administratifs et similaires avec une superficie accrue, où il y a plusieurs locaux adjacents dans un même bâtiment, des unités multi-split sont utilisées.
Chez LG, les multi-splits ont des modules internes qui maintiennent les paramètres d'air définis indépendamment des autres inclus dans le système, et sont contrôlés par une télécommande séparée. Ceci est dû au fait que chaque compresseur ne dessert que son propre bloc ou groupe de modules et est équipé d'un circuit frigorifique séparé. Les condenseurs en boucle sont une unité d'échange de chaleur traitée par un ventilateur, mais avec une circulation de fréon séparée. C'est pourquoi les modules internes ne dépendent pas les uns des autres et fonctionnent facilement dans différents modes.
Jusqu'à 9 unités intérieures peuvent être connectées à une unité extérieure LG. Les systèmes multi-split LG ont une puissance maximale de 16,4 kW.
Il convient de garder à l'esprit que le travail des modules doit se produire simultanément, soit uniquement pour le chaud, soit uniquement pour le froid.
Les multi-splits LG ont :
- dimensions nettes;
- un long parcours (options d'installation étendues);
- travail tranquille;
- de bons indicateurs d'efficacité énergétique grâce aux technologies d'onduleurs ;
- une plage étendue de températures de fonctionnement et leur correction rapide ;
- plusieurs vitesses de ventilation ;
- nettoyage de filtration en plusieurs étapes;
- système autonettoyant;
- fonctionnalité supplémentaire pour créer des conditions confortables pendant le repos ou lorsque l'appareil est à l'arrêt.
Étant donné que les lignes de modèles des modules internes et externes sont assez diverses, elles peuvent être combinées, créant plus de 150 options, chacune fonctionnant en tenant compte des caractéristiques d'une pièce particulière.
Systèmes multizones LG

Dans la climatisation de grands bâtiments à plusieurs étages, on utilise des systèmes multizones LG MULTI V, qui combinent toutes les technologies les plus modernes de contrôle électronique et de conception.
Dans ce système de type onduleur, jusqu'à plusieurs dizaines de modules VRV internes peuvent être connectés à une unité externe, dont la puissance totale atteindra plusieurs centaines de kW. Ils travaillent à leur tour indépendamment les uns des autres. Une telle installation est basée sur une technologie de réfrigérant variable économique, qui vous permet de répartir intelligemment la ressource en fonction des besoins de n'importe quelle pièce.
Un avantage significatif est un réseau unique de canalisations de fréon, ce qui simplifie l'installation et réduit considérablement la consommation d'énergie. La longueur accrue du parcours jusqu'à 200 m avec des dénivelés jusqu'à 100 m permet l'installation d'éléments du système sans tenir compte de l'emplacement d'un module particulier.
LG MULTI V est de nouvelles possibilités dans le domaine du contrôle, qui peuvent être effectuées à la fois à partir de télécommandes individuelles et à partir d'un système de télécommande centralisé.
Fiabilité, efficacité énergétique, productivité, respect de l'environnement, système de filtration à plusieurs étages, de nombreuses fonctions automatiques et confort sont les principaux avantages du LG MULTI V.
Instructions pour les climatiseurs et les télécommandes LG
Chaque climatiseur LG est livré avec un manuel d'utilisation séparé. Il comprend plusieurs rubriques :
- précautions et sécurité électrique;
- Information générale sur le produit;
- un manuel d'utilisation de l'appareil, qui comprend une description du fonctionnement et une télécommande pour le climatiseur LG ;
- soins et entretien.
Fondamentalement, le manuel du climatiseur LG contient des informations pour les installateurs concernant l'installation, la connexion et la mise en service de l'appareil.
Pour les utilisateurs, l'intérêt principal est la section dédiée aux instructions pour la télécommande des climatiseurs LG. La lecture de ces informations vous donnera une idée des réglages des principaux modes, fonctions et options. Comment contrôler les volets, comment allumer le climatiseur pour le chauffage, comment régler l'heure, comment activer l'option « SMART CLEAN » et d'autres points de fonctionnement sont décrits en détail et disponibles dans les instructions de la télécommande du climatiseur LG contrôler.
Tout d'abord, vous devez regarder le décodage des boutons sur le panneau de commande à distance. La télécommande sans fil du climatiseur LG possède environ le jeu de touches suivant :
- ALLUMÉ ÉTEINT - démarrage / arrêt de l'appareil ;
- VITESSE DU VENTILATEUR - contrôle de la vitesse du ventilateur ;
- MODE - choix des modes ;
- PLASMA - activation du mode purification d'air ;
- JET REFROIDISSEMENT - activation du mode de refroidissement accéléré ;
- TEMPÉRATURE - diminution/augmentation de la température de l'air ;
- FLUX D'AIR - direction des flux d'air ;
- TEMPS - mise à l'heure ;
- ENSEMBLE - Activer;
- DÉGAGER - dégager.
En plus des boutons avec des désignations de lettres, les climatiseurs LG ont également des boutons avec des symboles en forme sur la télécommande. Par exemple, une lumière allumée signifie régler la luminosité de l'écran, et le bouton avec l'image d'un thermomètre à l'intérieur de la maison affichera, lorsqu'il est enfoncé, la température extérieure.
Chaque modèle de n'importe quelle gamme d'appareils a un manuel séparé pour le panneau de commande du climatiseur LG, de sorte que l'utilisation d'un livret pour tous est impossible en raison de certaines différences fonctionnelles et techniques entre eux.
Schémas de câblage du climatiseur LG
Le kit doit inclure non seulement des instructions pour la télécommande du climatiseur LG et un manuel d'utilisation, mais également une documentation de service, dans laquelle vous pouvez trouver des informations sur les codes d'erreur et les schémas électriques des climatiseurs de ce fabricant. Ce schéma montre tous les composants de l'appareil et les communications fournies, c'est-à-dire les connexions.

Lors de la connexion, les installateurs sont guidés précisément par le circuit électrique du climatiseur LG, puisqu'il s'agit du document principal de l'appareil. Environ 20% des pannes de ces équipements sont associées à une mise en œuvre incorrecte de ce processus - l'utilisation d'un réseau non conçu pour des charges importantes et un câblage électrique mal installé.
Tous les schémas de circuits sont différents les uns des autres. Il n'existe pas de document unique pour tous les éléments de la technologie climatique, car certains peuvent contenir des composants qui ne sont pas présents dans d'autres.
Où puis-je trouver les schémas de câblage des climatiseurs LG, s'ils n'étaient pas inclus dans l'emballage ? Ils sont disponibles dans les centres de service et les revendeurs officiels de l'entreprise. Vous devez les contacter et faire une demande pour obtenir cette documentation technique.
Réparation de climatiseur LG

Tôt ou tard, n'importe quel climatiseur peut tomber en panne. L'utilisateur sera aidé à temps pour naviguer dans les erreurs des climatiseurs LG (d'une autre manière, les codes d'erreur), qui s'affichent sur l'écran de l'appareil ou sur la télécommande du climatiseur LG en cas de panne. Un dysfonctionnement est également signalé par le clignotement de la LED un certain nombre de fois pour chaque erreur. Pour les unités intérieures et extérieures, les désignations numériques et alphabétiques généralement acceptées sont complètement différentes. Dans les systèmes multi-split, elles diffèrent des valeurs des splits conventionnels. Il peut y avoir des différences dans le type de division.
Par exemple, pour le module interne du système split, un court-circuit ou un circuit ouvert du capteur de température de l'air est transmis par le code 06, pour le externe - 44.
Des informations complètes sur les erreurs des climatiseurs LG sont contenues dans la documentation technique fournie avec l'appareil ou dans le centre de service.
Toute panne implique d'appeler les maîtres qui diagnostiquent le problème et, si nécessaire, réparent les climatiseurs LG, à la fois dans l'établissement et au centre de service lui-même, en fonction de la complexité du cas particulier. Parmi les causes les plus courantes de dysfonctionnement des climatiseurs LG, les pannes se distinguent :
- compresseur;
- moteur de ventilateur;
- tableaux de commande;
- Vanne à 4 voies.
Dans tous les cas, les réparations nécessiteront des pièces de rechange pour le climatiseur LG, qui, à leur tour, sont beaucoup moins chères que l'achat d'un nouvel appareil.
Pour faciliter la recherche de telle ou telle pièce, il convient de rappeler que chaque pièce de rechange du climatiseur LG a son propre numéro de partie. Par exemple, la carte de commande du LG v48lh porte le numéro 6871A10025L et le compresseur du climatiseur LG, fonctionnant avec du fréon R22, est le QP442PBD.
Faire des économies dépend aussi de la qualité des diagnostics. Réparer un condensateur de démarrage reviendra beaucoup moins cher que de remplacer un compresseur de climatiseur LG, car la différence de prix entre ces pièces est très importante.
Un entretien régulier aidera à éviter de réparer les climatiseurs LG, qui comprend une gamme complète de travaux préventifs pour éliminer les pannes prématurées - nettoyage du système de drainage, du radiateur de l'unité extérieure, du système de filtrage, etc. Cela est particulièrement vrai pour les appareils installés dans des endroits surpeuplés.
Avis sur les climatiseurs LG
En général, les avis des clients sur les climatiseurs LG sont positifs. Les utilisateurs notent que ces appareils :
- travailler tranquillement;
- refroidir rapidement;
- consommer un minimum de ressources énergétiques (notamment les modèles onduleurs) ;
- facile à installer et facile à utiliser;
- certaines séries de fentes ont un design très inhabituel ;
- toutes les fonctions supplémentaires fonctionnent correctement.
La principale qualité positive des acheteurs dans leurs avis sur les climatiseurs LG s'appelle le segment de prix dans lequel se trouvent les appareils de cette marque. Le coût des climatiseurs LG conviendra au consommateur moyen avec un budget limité.
Dans les critiques, certains acheteurs notent le jaunissement du plastique des climatiseurs LG. Cela est dû à l'exposition directe au soleil et au tabagisme intense à l'intérieur. Mais un tel point négatif est présent dans la plupart des cas avec les anciens modèles de climatiseurs.








